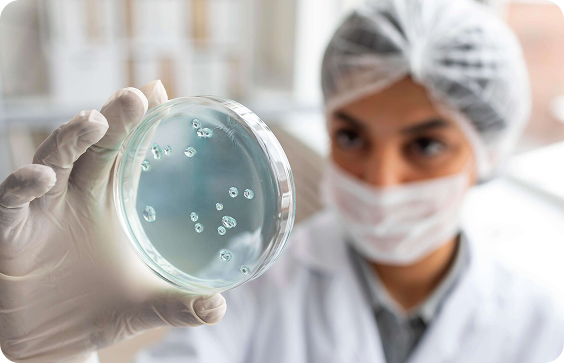

Who We Are
Who We Are
Dedicated To Advancing
Diagnostic Accuracy,
Every Day.
JTC Diagnostics is a Germany-based company with over two decades of experience in the field of in-vitro diagnostics (IVD). The company focuses on delivering high-quality diagnostic solutions that support accurate and reliable healthcare outcomes. With a strong foundation in innovation, expertise, and industry knowledge, JTC Diagnostics has established itself as a trusted partner in the global diagnostics sector. The organization continues to advance its capabilities to meet evolving healthcare needs and maintain excellence in diagnostic performance.

Your Trusted Diagnostic Partner
Thanks to its innovation and commitment to the sector, from its headquarters in Germany and with partners on several continents, JTC Diagnostics has experienced very significant growth that has led it to be present in more than 50 countries.
 Our Philosophy
Our Philosophy
Where Science, Precision, And Integrity Come Together

Commitment To The Sector
JTC Diagnostics™ is a German company that was born more than 20 years ago by its founder, Thomas Nolte, an entrepreneur and visionary with more than 30 years of experience in IVD, who managed to elevate the company and make it a world leader in the sector of the IVD.
Scientific Innovation
We seek to be at the forefront of innovation,
manufacturing and developing products that
help the IVD sector to position itself as a
business in constant growth and evolution,
offering the latest technological innovations.

Guarantee And Support
We respond to the growing global need for a
complete in vitro diagnostics business, prioritizing
customer satisfaction, whether in the context
of service, responsiveness, quality or product
innovation.
 Area Of Competence
Area Of Competence
Specialized Capabilities Across The Diagnostic Value Chain


Our Mission
Our mission is to meet the growing global need for a complete In Vitro Diagnostics products company: by providing our customers with innovative products and a service response capacity that fully meets
their needs. With the firm commitment to comply with all legal and regulatory requirements for all its products.

Our Vision
Good judgment, honesty and integrity are part of our culture. We provide a customer oriented and results-oriented service thanks to our group of manufacturing and product experts.
We encourage our employees and representatives to push the
boundaries of excellence in everything they do.

Our Quality
Continuous quality improvement is part of the DNA of all JTC Diagnostics employees and representatives. Our customers are foremost in our mind, offering excellence in quality through the highest standards of communication and training.
Do You Want a Partner With More Than 30 Years Of Experience?
Our long-term commitment to science, quality, and innovation allows us to deliver consistent, future-ready IVD technologies trusted by partners across the globe.
